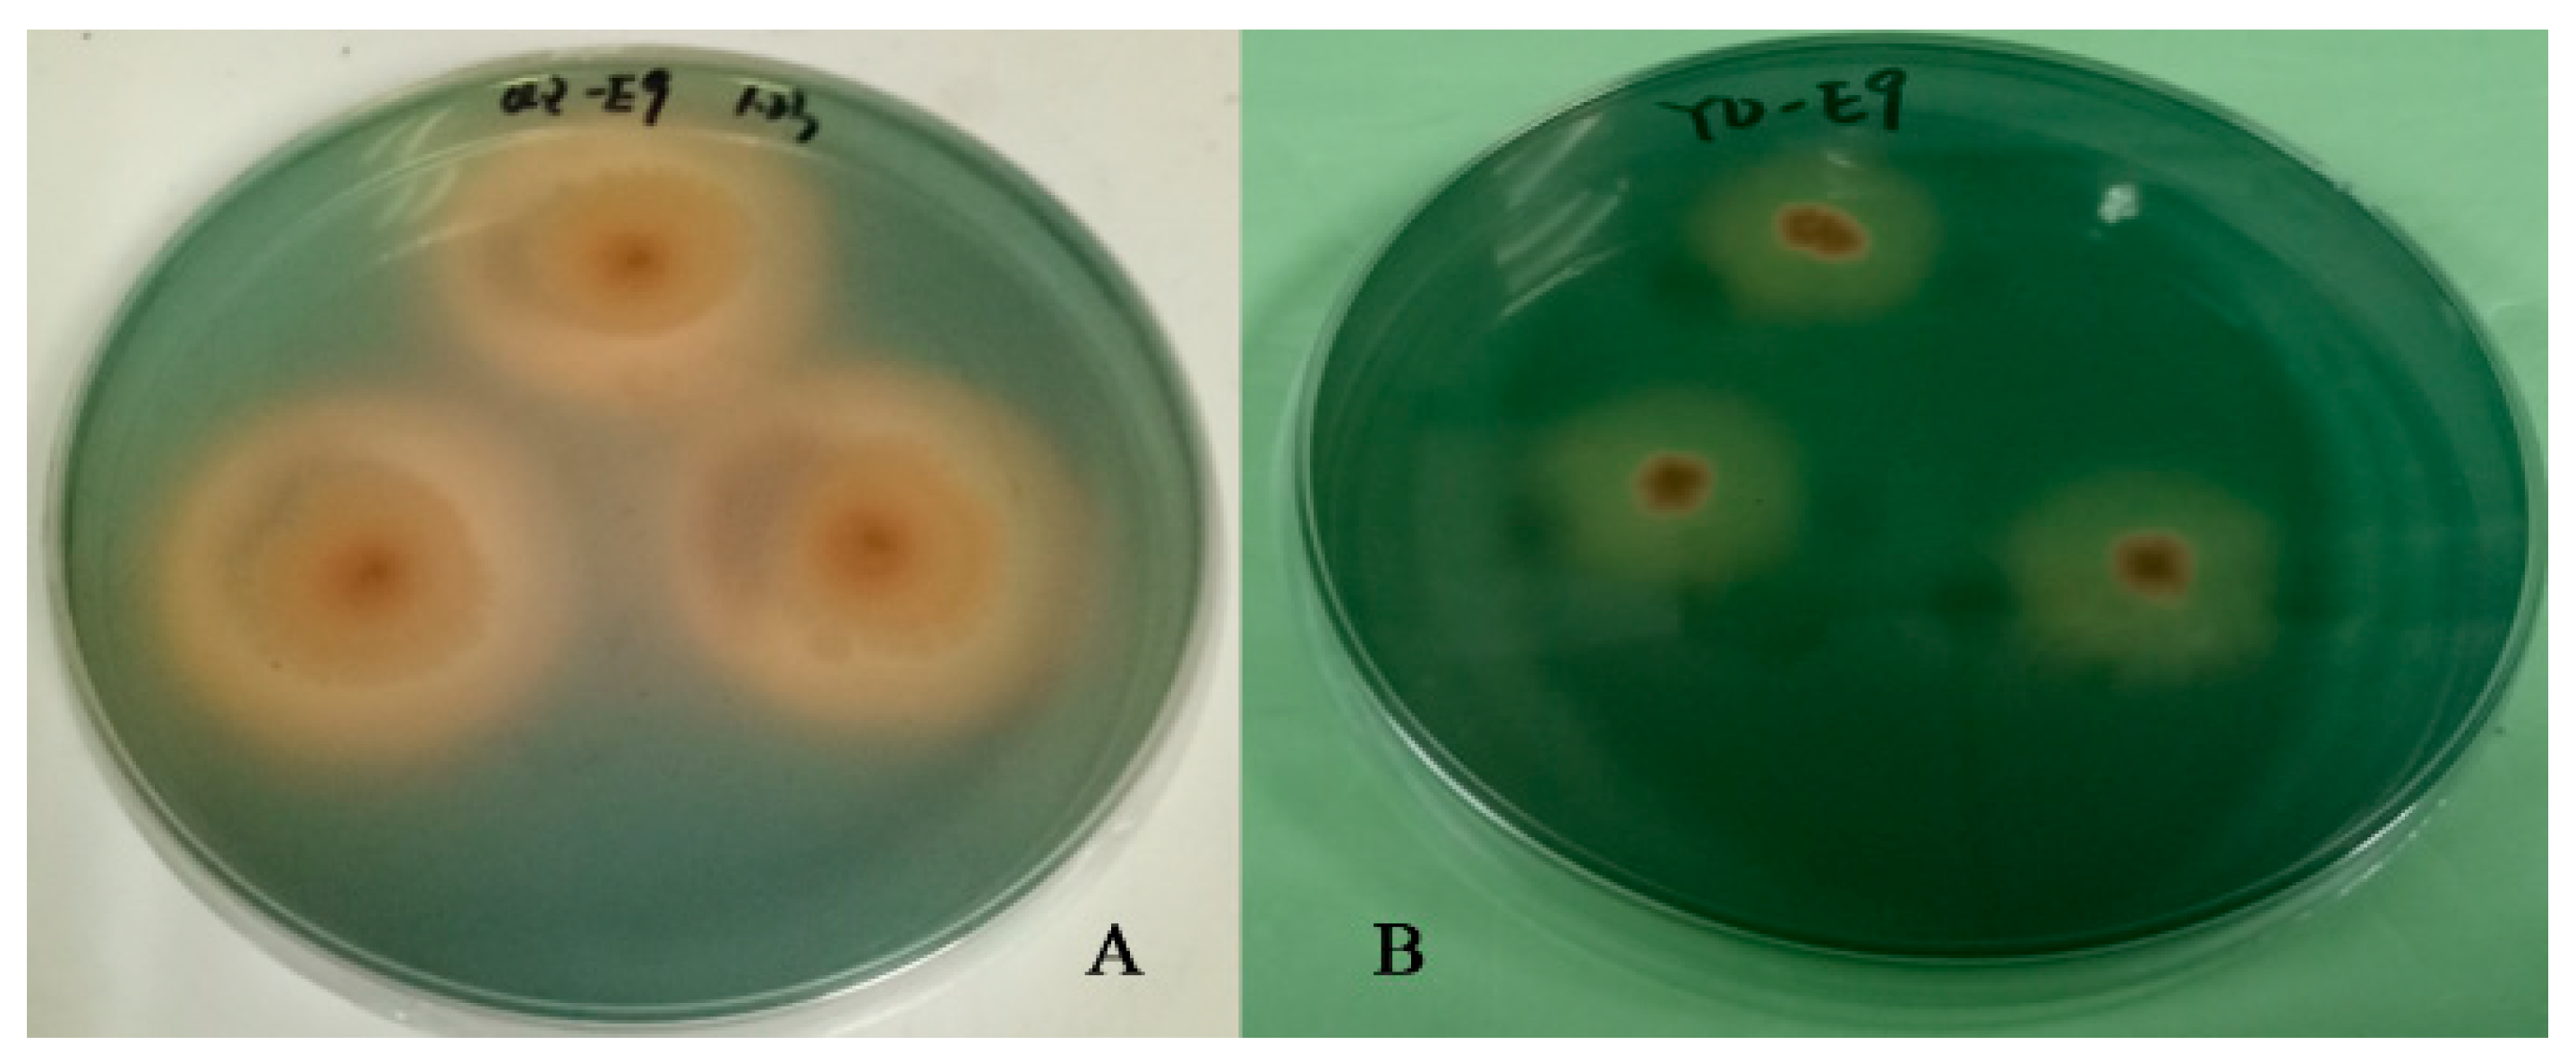
Plants 13 02703 g002

Isolation and Plant Growth Promotion Effect of Endophytic Siderophore-Producing Bacteria: A Study on Halophyte Sesuvium portulacastrum
Abstract
1. Introduction
2. Results
2.1. Isolation of and Identification of Endophytes
2.2. Screening of Siderophore-Producing Bacteria and Results of Activity Assay
2.3. Relationship between Siderophore-Producing Activity and Iron Ion Concentration in the Siderophore-Producing High-Yielding Bacterium Erwinia sp. QZ-E9
2.4. Results of Simulation Experiments on Root Regression of Plant-Promoting Bacteria
2.4.1. Effect of Erwinia sp. QZ-E9 on the Growth of S. portulacastrum
2.4.2. Erwinia sp. QZ-E9 Colonization in S. portulacastrum
3. Discussion
3.1. Endophytic Bacteria and Plant Growth Promotion
3.2. Siderophores and Heavy Metal Stress Alleviation
3.3. Potential Applications in Phytoremediation
4. Materials and Method
4.1. Plant Material and Bacterial Strains
4.2. Root Treatment and Isolation of Endophytic Bacteria in S. portulacastrum
4.3. Screening and Activity Determination of Siderophore-Producing Bacteria
4.4. Method for Determining the Relationship between Siderophore-Producing Activity and Iron Ion Concentration in the Siderophore-Producing Bacterium Strain QZ-E9
4.5. Simulation Experiment on Root Regression of Plant-Promoting Bacteria
4.6. Detection of Bacterial Colonization
5. Conclusions
Author Contributions
Funding
Data Availability Statement
Conflicts of Interest
References
- Sam Cherian, S.L.; Nele, W.; Vangronsveld, J. Phytoremediation of Trace Element–Contaminated Environments and the Potential of Endophytic Bacteria for Improving This Process. Crit. Rev. Environ. Sci. Technol. 2012, 42, 2215–2260. [Google Scholar] [CrossRef]
- Laller, R.; Khosla, P.K.; Negi, N.; Avinash, H.; Kusum; Thakur, N.; Kashyap, S.; Shukla, S.K.; Hussain, I. Bacterial Volatiles as PGPRs: Inducing Plant Defense Mechanisms during Stress Periods. S. Afr. J. Bot. 2023, 159, 131–139. [Google Scholar] [CrossRef]
- Saha, M.; Sarkar, S.; Sarkar, B.; Sharma, B.K.; Bhattacharjee, S.; Tribedi, P. Microbial Siderophores and Their Potential Applications: A Review. Environ. Sci. Pollut. Res. 2016, 23, 3984–3999. [Google Scholar] [CrossRef]
- Sujatha, N.T.; Ammani, K. Siderophore Production by the Isolates of Fluorescent Pseudomonads. Int. J. Curr. Res. Rev. 2013, 5, 01–07. [Google Scholar]
- Sun, Y.; Wu, J.; Shang, X.; Xue, L.; Ji, G.; Chang, S.; Niu, J.; Emaneghemi, B. Screening of Siderophore-Producing Bacteria and Their Effects on Promoting the Growth of Plants. Curr. Microbiol. 2022, 79, 150. [Google Scholar] [CrossRef]
- Sultana, S.; Alam, S.; Karim, M.M. Screening of Siderophore-Producing Salt-Tolerant Rhizobacteria Suitable for Supporting Plant Growth in Saline Soils with Iron Limitation. J. Agric. Food Res. 2021, 4, 100150. [Google Scholar] [CrossRef]
- Lokhande, V.H.; Nikam, T.D.; Suprasanna, P. Sesuvium portulacastrum (L.) L. a Promising Halophyte: Cultivation, Utilization and Distribution in India. Genet. Resour. Crop Evol. 2009, 56, 741–747. [Google Scholar] [CrossRef]
- Fourati, E.; Wali, M.; Vogel-Mikuš, K.; Abdelly, C.; Ghnaya, T. Nickel Tolerance, Accumulation and Subcellular Distribution in the Halophytes Sesuvium portulacastrum and Cakile maritima. Plant Physiol. Biochem. 2016, 108, 295–303. [Google Scholar] [CrossRef]
- Lokhande, V.H.; Patade, V.Y.; Srivastava, S.; Suprasanna, P.; Shrivastava, M.; Awasthi, G. Copper Accumulation and Biochemical Responses of Sesuvium portulacastrum (L.). Mater. Today Proc. 2020, 31, 679–684. [Google Scholar] [CrossRef]
- Zhao, S.; Zhou, N.; Zhao, Z.-Y.; Zhang, K.; Tian, C.-Y. High-Throughput Sequencing Analysis of the Endophytic Bacterial Diversity and Dynamics in Roots of the Halophyte Salicornia Europaea. Curr. Microbiol. 2016, 72, 557–562. [Google Scholar] [CrossRef]
- Amann, R.I.; Binder, B.J.; Olson, R.J.; Chisholm, S.W.; Devereux, R.; Stahl, D.A. Combination of 16S rRNA-Targeted Oligonucleotide Probes with Flow Cytometry for Analyzing Mixed Microbial Populations. Appl. Environ. Microbiol. 1990, 56, 1919–1925. [Google Scholar] [CrossRef]
- Bohnert, J.; Hübner, B.; Botzenhart, K.; Bohnert, J. Rapid Identification of Enterobacteriaceae Using a Novel 23S rRNA-Targeted Oligonucleotide Probe. Int. J. Hyg. Environ. Health 2000, 203, 77–82. [Google Scholar] [CrossRef]
- Kong, Z.; Glick, B.R. Chapter Two—The Role of Plant Growth-Promoting Bacteria in Metal Phytoremediation. In Advances in Microbial Physiology; Poole, R.K., Ed.; Academic Press: Cambridge, MA, USA, 2017; Volume 71, pp. 97–132. [Google Scholar]
- Ahemad, M.; Kibret, M. Mechanisms and Applications of Plant Growth Promoting Rhizobacteria: Current Perspective. J. King Saud Univ. Sci. 2014, 26, 1–20. [Google Scholar] [CrossRef]
- Yi, S.; Wei, M.; Li, F.; Liu, X.; Fan, Q.; Lu, H.; Wu, Y.; Liu, Y.; Tian, J.; Zhang, M. In-Situ Enrichment of ARGs and Their Carriers in Soil by Hydroxamate Siderophore: A Promising Biocontrol Approach for Source Reduction. Environ. Int. 2024, 190, 108915. [Google Scholar] [CrossRef]
- Li, B.; Wu, B.; Dong, Y.; Lin, H.; Liu, C. Endophyte Inoculation Enhanced Microbial Metabolic Function in the Rhizosphere Benefiting Cadmium Phytoremediation by Phytolacca Acinosa. Chemosphere 2023, 338, 139421. [Google Scholar] [CrossRef]
- Orozco-Mosqueda, M.d.C.; Glick, B.R.; Santoyo, G. ACC Deaminase in Plant Growth-Promoting Bacteria (PGPB): An Efficient Mechanism to Counter Salt Stress in Crops. Microbiol. Res. 2020, 235, 126439. [Google Scholar] [CrossRef]
- Gomes, A.F.R.; Almeida, M.C.; Sousa, E.; Resende, D.I.S.P. Siderophores and Metallophores: Metal Complexation Weapons to Fight Environmental Pollution. Sci. Total Environ. 2024, 932, 173044. [Google Scholar] [CrossRef]
- Kim, D.; Duckworth, O.W.; Strathmann, T.J. Hydroxamate Siderophore-Promoted Reactions between Iron(II) and Nitroaromatic Groundwater Contaminants. Geochim. Cosmochim. Acta 2009, 73, 1297–1311. [Google Scholar] [CrossRef]
- Dimkpa, C.O.; Merten, D.; Svatoš, A.; Büchel, G.; Kothe, E. Siderophores Mediate Reduced and Increased Uptake of Cadmium by Streptomyces Tendae F4 and Sunflower (Helianthus annuus), Respectively. J. Appl. Microbiol. 2009, 107, 1687–1696. [Google Scholar] [CrossRef]
- Zhao, Z.; Liu, L.; Sun, Y.; Xie, L.; Liu, S.; Li, M.; Yu, Q. Combined Microbe-Plant Remediation of Cadmium in Saline-Alkali Soil Assisted by Fungal Mycelium-Derived Biochar. Environ. Res. 2024, 240, 117424. [Google Scholar] [CrossRef]
- Qiu, H.; Xu, J.; Yuan, Y.; Alesi, E.J.; Liang, X.; Cao, B. Low-Disturbance Land Remediation Using Vertical Groundwater Circulation Well Technology: The First Commercial Deployment in an Operational Chemical Plant. Sci. Total Environ. 2024, 944, 173804. [Google Scholar] [CrossRef]
- Schwyn, B.; Neilands, J.B. Universal Chemical Assay for the Detection and Determination of Siderophores. Anal. Biochem. 1987, 160, 47–56. [Google Scholar] [CrossRef]
- Kumar, P.; Thakur, S.; Dhingra, G.K.; Singh, A.; Pal, M.K.; Harshvardhan, K.; Dubey, R.C.; Maheshwari, D.K. Inoculation of Siderophore Producing Rhizobacteria and Their Consortium for Growth Enhancement of Wheat Plant. Biocatal. Agric. Biotechnol. 2018, 15, 264–269. [Google Scholar] [CrossRef]
- Kliot, A.; Ghanim, M. Fluorescent in Situ Hybridization for the Localization of Viruses, Bacteria and Other Microorganisms in Insect and Plant Tissues. Methods 2016, 98, 74–81. [Google Scholar] [CrossRef]

| Strains | Reference Bacteria of Highest Similarities | Similarities |
|---|---|---|
| QZ-E1 | Microbacterium pumilum KV-488(T) | 98.96 |
| QZ-E2 | Agromyces kandeliae Q22(T) | 98.89 |
| QZ-E3 | Microbacterium fluvii YSL3-15(T) | 99.36 |
| QZ-E4 | Microbacterium pumilum KV-488(T) | 97.70 |
| QZ-E5 | Auramtiacibacter aquimixticola JSSK-14(T) | 97.55 |
| QZ-E6 | Roseibium litorale 4C16A(T) | 99.70 |
| QZ-E7 | Devosia naphthalenivorans CM5-1(T) | 97.84 |
| QE-E8 | Qipengyuania citrea RE35F/1(T) | 97.77 |
| QZ-E9 | Erwinia rhpontici ATCC 29283(T) | 98.67 |
| QZ-E10 | Microbacterium schleiferi IFO 15075(T) | 99.15 |
| QZ-E11 | Microbacterium schleiferi IFO 15075(T) | 98.65 |
| QZ-E12 | Devosia naphthalenivorans CM5-1(T) | 97.05 |
| QZ-E13 | Roseibium aggregatum IAM 12614(T) | 98.99 |
| QZ-E14 | Rossellomorea oryzaecorticis R1(T) | 98.25 |
| QZ-E15 | Alkalihalobacillues algicola KMM 3737(T) | 99.10 |
| QZ-E16 | Rossellomorea marisflavi TF-11(T) | 99.11 |
| QZ-E17 | Qipengyuania polymorpha 1NDH17(T) | 98.56 |
| QZ-E18 | Alterricroceibacterium indicum MSSRF26(T) | 99.93 |
| QZ-E19 | Microbacterium testaceum NBRC 12675(T) | 98.31 |
| QZ-E20 | Qipengyuania polymorpha 1NDH17(T) | 99.06 |
| QZ-E21 | Parasphingorhabdus pacifica KMM9574(T) | 98.20 |
| QZ-E22 | Aurantiacibacter arachoides RC4-10-4(T) | 98.84 |
| QZ-E23 | Roseibium aggregatum IAM 12614(T) | 98.84 |
| QZ-E24 | Alterricroceibacterium indicum MSSRF26(T) | 99.93 |
| QZ-E25 | Marinomonas primoryensis KMM3633(T) | 97.59 |
| QZ-E26 | Devosia humi THG-MM1(T) | 95.49 |
| QZ-E27 | Qipengyuania vulgaris 022 2-10(T) | 99.93 |
| QZ-E28 | Qipengyuania xiapuensis 1NDW9(T) | 98.27 |
| QZ-E29 | Lactococcus lactis subsp. lactis JCM 5805(T) | 98.49 |
| QZ-E30 | Microbacterium schleiferi IFO 15075(T) | 99.22 |
| QZ-E31 | Algoriphagus halophilus DSM 15292(T) | 98.66 |
| QZ-E32 | Aestuariibaculum suncheonense SC17(T) | 97.94 |
| QZ-E33 | Erythrobacter westpacificensis JLT 2008(T) | 97.57 |
| Strains | Genus | SU% | SU Activity |
|---|---|---|---|
| QZ-E6 | Roseibium | 27.51 | ++ |
| QZ-E9 | Erwinia | 80.39 | +++++ |
| QZ-E13 | Roseibium | 48.59 | +++ |
| QZ-E14 | Rossellomorea | 59.51 | +++ |
| QZ-E16 | Rossellomorea | 29.66 | ++ |
| QZ-E17 | Qipengyuania | 14.00 | + |
| QZ-E19 | Microbacterium | 13.90 | + |
| QZ-E20 | Qipengyuania | 13.03 | + |
| QZ-E23 | Roseibium | 11.90 | + |
| QZ-E31 | Algoriphagus | 20.99 | ++ |
| Time | QZ-E9 (0 μmol/L) | QZ-E9 (2 μmol/L) | QZ-E9 (50 μmol/L) | |||
|---|---|---|---|---|---|---|
| P | P + B | P | P + B | P | P + B | |
| 7 d | 0 | 0 | 0 | 0 | 0 | 2 |
| 14 d | 1 | 2 | 0 | 2 | 0 | 2 |
| 21 d | 1 | 3 | 2 | 6 | 1 | 4 |
| 28 d | 1 | 4 | 3 | 7 | 1 | 4 |
| Major Element Nutrient Solution | Trace Element Nutrient Solution | ||
|---|---|---|---|
| Formulation | Concentration 1.0 × 10−3 mol/L | Formulation | Concentration 1.0 × 10−6 mol/L |
| Ca(NO3)·4H2O | 2.0 | H3BO3 | 1.0 |
| K2SO4 | 0.75 | MnSO4·H2O | 1.0 |
| KCl | 0.10 | ZnSO4·7H2O | 1.0 |
| KH2PO4 | 0.25 | CuSO4·5H2O | 0.10 |
| MgSO4·7H2O | 0.65 | (NH4)MoO4·4H2O | 5.0 × 10−3 |
Disclaimer/Publisher’s Note: The statements, opinions and data contained in all publications are solely those of the individual author(s) and contributor(s) and not of MDPI and/or the editor(s). MDPI and/or the editor(s) disclaim responsibility for any injury to people or property resulting from any ideas, methods, instructions or products referred to in the content. |
© 2024 by the authors. Licensee MDPI, Basel, Switzerland. This article is an open access article distributed under the terms and conditions of the Creative Commons Attribution (CC BY) license (https://creativecommons.org/licenses/by/4.0/).
Share and Cite
Cen, X.; Li, H.; Zhang, Y.; Huang, L.; Luo, Y. Isolation and Plant Growth Promotion Effect of Endophytic Siderophore-Producing Bacteria: A Study on Halophyte Sesuvium portulacastrum. Plants 2024, 13, 2703. https://doi.org/10.3390/plants13192703
Cen X, Li H, Zhang Y, Huang L, Luo Y. Isolation and Plant Growth Promotion Effect of Endophytic Siderophore-Producing Bacteria: A Study on Halophyte Sesuvium portulacastrum. Plants. 2024; 13(19):2703. https://doi.org/10.3390/plants13192703
Chicago/Turabian StyleCen, Xinyi, Hua Li, Yanhua Zhang, Lingfeng Huang, and Yuanrong Luo. 2024. "Isolation and Plant Growth Promotion Effect of Endophytic Siderophore-Producing Bacteria: A Study on Halophyte Sesuvium portulacastrum" Plants 13, no. 19: 2703. https://doi.org/10.3390/plants13192703
APA StyleCen, X., Li, H., Zhang, Y., Huang, L., & Luo, Y. (2024). Isolation and Plant Growth Promotion Effect of Endophytic Siderophore-Producing Bacteria: A Study on Halophyte Sesuvium portulacastrum. Plants, 13(19), 2703. https://doi.org/10.3390/plants13192703





